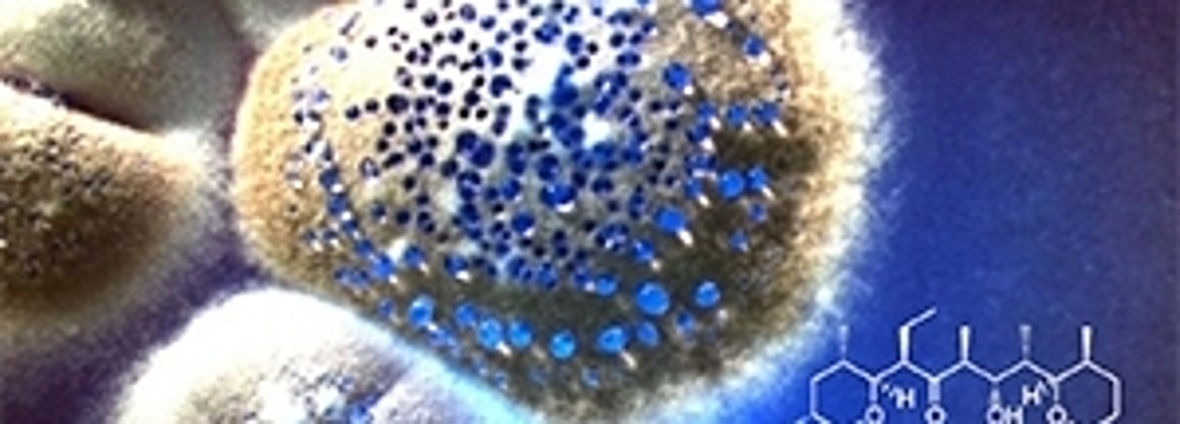

IBL-research interview: Daniel Rozen
Daniel Rozen (45), at the IBL since September 2012, uses bacteria in laboratory tests on experimental evolution to study the ecology and genetics of adaptation. His research has applied importance, as it reveals how bacteria may be induced to produce new antibiotics. Last January, Rozen received the title: “Discoverer of the year 2015”.

Fundamental Interests
Rozen’s work reflects his fundamental interests in evolution and spans very diverse topics, including the genetics of adaptation, the evolution of recombination in bacteria, the roles of species interactions in microbial antagonism and the interactions of bacteria with insects. Work on Streptomyces actinobacteria is currently his main focus and was initiated in Leiden through collaborations with Prof. dr. Gilles van Wezel and Dr. Dennis Claessen.
Motivation

Daniel Rozen’s Streptomyces work is motivated by a desire to understand the existence and role of antibiotics in nature. However, there is clear societal relevance to this understanding for antibiotic discovery. Rozen and his colleagues work for example with the pathogen Streptococcus pneumoniae on antibacterial proteins, called bacteriocins: “While we are primarily working to understand diversity and evolution, we are well aware of the potential value of these products for therapy. We therefore seek to collaborate with industrial partners that are better able to exploit this aspect of our results.”
Rozen hopes that the efforts of he and his colleagues lead to the identification of interesting new antibiotics or antifungals, and also yield insights into the factors that are responsible for their stable production. Rozen: “We hope to identify factors that underlie genetic instability in Streptomyces and thereby reduce strain degeneration during industrial processes”.
Plans for a bright future
In the coming years, Daniel Rozen and his colleagues will continue their work with Streptomyces and they will be heading into several different directions. A selection (from a big list): “First, we are expanding our studies of interactions between strains and species as elicitors of antibiotics. Second, we are working towards a mechanistic and evolutionary understanding of genomic instability in this genus. Third, we are developing new projects in collaboration with Dennis Claessen on the evolution of cellular and multicellular complexity. Many other plans are in development.” - says Rozen.
